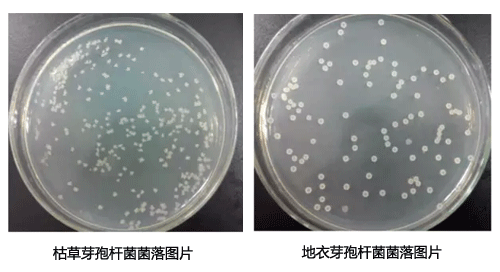
地衣芽孢桿菌和枯草芽孢桿菌菌落對(duì)比圖片

枯草和地衣芽孢桿菌之所以作為最常見的兩種益生菌,是因?yàn)檫@兩種益生菌具有較好的抗氧化、抗擠壓、耐高溫及耐酸堿等性能,進(jìn)入消化道后,可迅速由休眠狀態(tài)復(fù)活,在短期內(nèi)繁殖成高含菌量的優(yōu)勢(shì)種群,消耗掉腸道內(nèi)大量氧氣,建立微生態(tài)平衡,可起到預(yù)防多種疾病和促生長(zhǎng)的作用。了解地衣芽孢桿菌和枯草芽孢桿菌的廠家則能很好的分辨它們。但不了解地衣和枯草芽孢桿菌的個(gè)人則很難分清這兩種芽孢桿菌。以下詳細(xì)介紹了地衣芽孢桿菌和芽孢桿菌的區(qū)別。從菌落的外觀來看,則可很好的區(qū)分這兩種芽孢桿菌。枯草和地衣芽孢桿菌的菌落較大,呈規(guī)則圓形,菌落很厚實(shí),白色略發(fā)黃;地衣芽胞桿菌則菌落較小,呈不規(guī)則形狀,邊緣不整齊,菌落松散,培養(yǎng)時(shí)間延長(zhǎng)到48h以上可看到菌落呈微紅色。 其次,可通過丙酸鈉發(fā)酵管鑒別它們。鑒定管配方如下:蛋白胨5g,氯化鈉3g,磷酸氫二鉀2g,1%溴百里酚藍(lán)乙醇溶液10ml,蒸餾水1000ml,PH7.2。配置后分裝15*150試管,每管4ml,接種各菌株后37℃,200r/min培養(yǎng)18h后,觀察鑒定管變色情況,變藍(lán)為地衣,綠色為枯草。通過以上方式,則能很好的區(qū)別地衣芽孢桿菌和枯草芽孢桿菌,不需進(jìn)行細(xì)菌16SrDNA鑒定的方式,避免了存在費(fèi)用高、耗時(shí)長(zhǎng),檢測(cè)設(shè)備要求高等缺點(diǎn)。枯草和地衣芽孢桿菌在發(fā)酵過程中會(huì)出現(xiàn)大量泡沫,泡沫的產(chǎn)生則會(huì)導(dǎo)致枯草芽孢桿菌發(fā)酵發(fā)生逃液。因此,要想消除泡沫,必須添加消泡劑。
其次,可通過丙酸鈉發(fā)酵管鑒別它們。鑒定管配方如下:蛋白胨5g,氯化鈉3g,磷酸氫二鉀2g,1%溴百里酚藍(lán)乙醇溶液10ml,蒸餾水1000ml,PH7.2。配置后分裝15*150試管,每管4ml,接種各菌株后37℃,200r/min培養(yǎng)18h后,觀察鑒定管變色情況,變藍(lán)為地衣,綠色為枯草。通過以上方式,則能很好的區(qū)別地衣芽孢桿菌和枯草芽孢桿菌,不需進(jìn)行細(xì)菌16SrDNA鑒定的方式,避免了存在費(fèi)用高、耗時(shí)長(zhǎng),檢測(cè)設(shè)備要求高等缺點(diǎn)。枯草和地衣芽孢桿菌在發(fā)酵過程中會(huì)出現(xiàn)大量泡沫,泡沫的產(chǎn)生則會(huì)導(dǎo)致枯草芽孢桿菌發(fā)酵發(fā)生逃液。因此,要想消除泡沫,必須添加消泡劑。 煙臺(tái)恒鑫化工科技有限公司研發(fā)生產(chǎn)的發(fā)酵用消泡劑可有效消滅泡沫,并抑制泡沫的產(chǎn)生,效果顯著,是枯草芽孢桿菌發(fā)酵行業(yè)專用的消泡劑,具有消泡速度快,抑泡時(shí)間久的特點(diǎn),廣泛應(yīng)用于微生物發(fā)酵領(lǐng)域。發(fā)酵用消泡劑應(yīng)用在枯草芽孢桿菌發(fā)酵,具有消泡快,抑泡久的特點(diǎn),適用范圍廣,如抗生素、維生素C、賴氨酸、青霉素、酶制劑、頭孢、氨基酸等各種菌種的生產(chǎn)發(fā)酵過程的消泡,如需詳詢THIX-298發(fā)酵用消泡劑用于枯草芽孢桿菌的發(fā)酵消泡可致電消泡劑生產(chǎn)廠家05358015296,歡迎索取樣品試用。
煙臺(tái)恒鑫化工科技有限公司研發(fā)生產(chǎn)的發(fā)酵用消泡劑可有效消滅泡沫,并抑制泡沫的產(chǎn)生,效果顯著,是枯草芽孢桿菌發(fā)酵行業(yè)專用的消泡劑,具有消泡速度快,抑泡時(shí)間久的特點(diǎn),廣泛應(yīng)用于微生物發(fā)酵領(lǐng)域。發(fā)酵用消泡劑應(yīng)用在枯草芽孢桿菌發(fā)酵,具有消泡快,抑泡久的特點(diǎn),適用范圍廣,如抗生素、維生素C、賴氨酸、青霉素、酶制劑、頭孢、氨基酸等各種菌種的生產(chǎn)發(fā)酵過程的消泡,如需詳詢THIX-298發(fā)酵用消泡劑用于枯草芽孢桿菌的發(fā)酵消泡可致電消泡劑生產(chǎn)廠家05358015296,歡迎索取樣品試用。
手機(jī):18396600176 電話:0535-8015296 EMAIL:[email protected]
公司地址:山東省煙臺(tái)市開發(fā)區(qū)武漢大街19號(hào)
?2016恒鑫化工 魯ICP備05045800號(hào)-13 xml地圖
聯(lián)系電話
微信掃一掃
